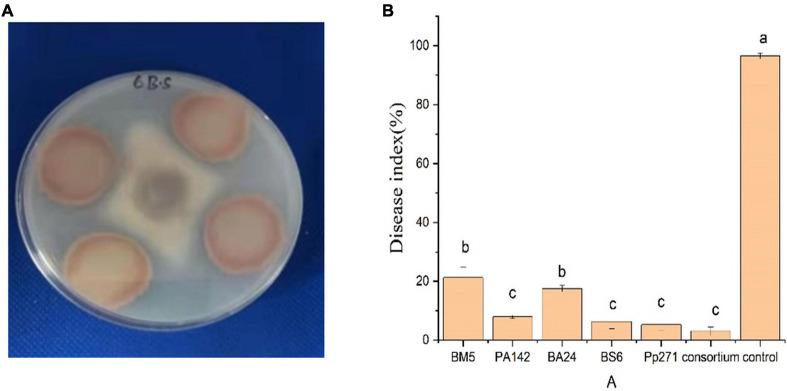
https://cdn.ncbi.nlm.nih.gov/pmc/blobs/60d5/8555416/2c3e90d818a3/fmicb-12-731764-g007.jpg

番茄内生细菌组成及对青枯病的抑制机制()
Tomato Endophytic Bacteria Composition and Mechanism of Suppressiveness of Wilt Disease ().
作者信息
Zhang Zeyu, Li Ji, Zhang Zengqiang, Liu Youzhou, Wei Yuquan
机构信息
College of Resources and Environmental Science, China Agricultural University, Beijing, China.
College of Natural Resources and Environment, Northwest A&F University, Xianyang, China.
出版信息
Front Microbiol. 2021 Oct 15;12:731764. doi: 10.3389/fmicb.2021.731764. eCollection 2021.
Tomato wilt disease, caused by the is an ever-increasing threat for agricultural production, and unreasonable fertilization and pesticide abuse caused environmental challenge. Increasing evidence suggested that microbiomes or those associated with crops, played key roles on plant health. Plant disease dynamics were affected by multiple biotic and abiotic factors including phytopathogen population density, the genetic type of the pathogen and the host, in particular, the composition and assembly of the host-associated microbiome. However, it was unclear how pathogen invasion interaction and correlate with endophytic bacterial communities in natural field conditions. To study this, we sampled temporally the tomato plants that were exposed to invasions over one crop season. High-throughput sequencing were performed to explore the correlation between agricultural practice, pathogen invasion, and endophytic microbiota communities. Results showed that pathogen invasion had clear effect on the endophytic and a strong link between increased pathogen densities and reduced abundance of sp., which are crucial taxonomy for suppressiveness to and in greenhouse condition. In summary, monitoring the dynamics of endophytic bacteria communities and densities of pathogen could thus open new avenue for more accurate disease diagnostics and high-efficiency screening antagonisms methods in the future, and our results will broaden the agricultural view of beneficial microbiota as biological control agents against plant pathogen.
番茄枯萎病由[病原体名称未给出]引起,对农业生产构成日益严重的威胁,不合理施肥和滥用农药带来了环境挑战。越来越多的证据表明,微生物群落或与作物相关的微生物群落对植物健康起着关键作用。植物病害动态受多种生物和非生物因素影响,包括植物病原体种群密度、病原体和宿主的遗传类型,特别是与宿主相关的微生物群落的组成和组装。然而,在自然田间条件下,病原体入侵如何与内生细菌群落相互作用并相关尚不清楚。为了研究这一点,我们在一个作物季节内对遭受[病原体名称未给出]入侵的番茄植株进行了定期采样。进行高通量测序以探索农业实践、病原体入侵和内生微生物群落之间的相关性。结果表明,病原体入侵对内生菌有明显影响,病原体密度增加与[未明确的菌种名称]丰度降低之间存在强烈关联,[未明确的菌种名称]在抑制[病原体名称未给出]方面以及在温室条件下是关键分类群。总之,监测内生细菌群落动态和病原体密度可能为未来更准确的疾病诊断和高效筛选拮抗方法开辟新途径,我们的结果将拓宽将有益微生物群落视为对抗植物病原体的生物防治剂的农业视野。